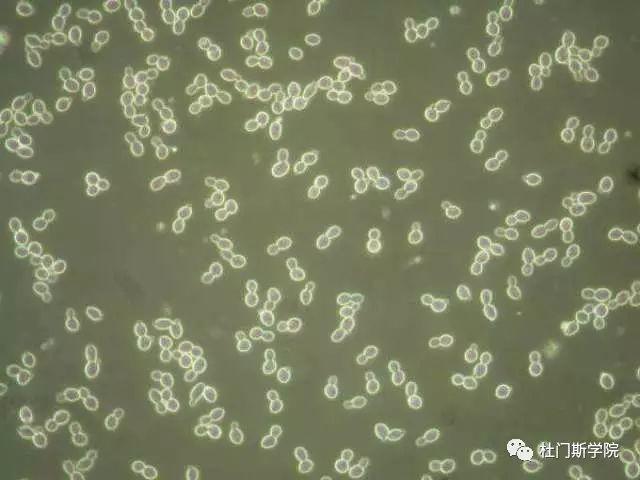
酵母和啤酒发酵产生的风味 酵母和啤酒发酵产生的风味

在啤酒生产中酵母菌体不是最终产品,但对最终产品啤酒的质量确是重要的。酵母生产菌株的选择最重要的是发酵麦芽汁的速度和麦芽汁的发酵度,啤酒酵母除在发酵时形成酒精和二氧化碳外,还产生一定数量和种类的副产物,这些副产物有:高级醇、醛和酮、酯类、双乙酰、硫化合物、脂肪酸和有机酸,这些副产物对啤酒的口味和气味影响很大。这些特性首先决定于酵母细胞的酶活性,与酵母细胞种类及其浓度有关,不同的酵母菌株产生副产物的量不同,种类也有差异。因此,为选育啤酒酵母及发酵工艺的正确进行,对一些菌株的性质要有一定的认识。同时,必须注意到,酵母菌株具有各种不同的性状,其中一些性质是不断变化的,将引起发酵指标的改变。
优良的酵母的概念,应该是具有高发酵度,凝聚性好,有效地除去双乙酰,给啤酒以理想的理化性状和完美口味的酵母菌种。

高级醇类
啤酒中绝大多数的高级醇是在主发酵旺盛期间形成的,生成高级醇的发酵途径主要有降解代谢途径和合成代谢途径。
啤酒中的各种高级醇的感官阈值和啤酒的类型有关,并受啤酒中所有风味物质组成成分的影响。有研究说高级醇与其他风味物质组分混合在一起时会有加成效应。戊醇与苯乙醇结合在一起时成为高级醇中对啤酒风味最具有影响的因素。一般来说,异戊醇的含量在各高级醇中是最高的,异戊醇含量高的啤酒,饮用者要相对降低酒量。
醛和酮
乙醛是乙醇发酵的正常前驱物质,是由丙酮酸不可逆地经丙酮酸脱羧酶的作用被催化而形成的。乙醛和双乙酰是啤酒中两个比较重要的羰基化合物,且对啤酒的风味有重要的影响。在发酵的最后阶段,乙醛因酒精脱氢酶的酶促反应还原成乙醇,少部分乙醛氧化成乙酸。乙醛有多少被还原,又有多少被氧化是受发酵时酒精浓度所支配的。乙醛的含量在发酵及贮存时有所变化,乙醛大量形成于主发酵前期,当下面发酵在发酵度在35%-60%时乙醛含量最高,有时可以产生两个高峰值,而后很快下降。
乙醛影响啤酒口味的成熟,当啤酒中乙醛含量超过阈值时,给人以不愉快的粗糙感,含量过高,有一种辛辣的腐烂青草味。但是改变啤酒中乙醛的含量并不能如预期那样达到改善啤酒风味的效果。有研究在乙醛与双乙酰和硫化氢并存时,就构成了嫩啤酒的那种固有的生青味。啤酒中的主要酮类是丙酮,但含量极微,对风味无影响,大概是异丙醇的前驱物质,来自乙酰醋酸。
酯类
啤酒中的酯类大部分是在发酵时形成的,但有些是在啤酒成熟期形成的,啤酒中酯类含量虽少,但对啤酒风味影响很大,它的形成与酵母的类脂物代谢有关。
在发酵时形成酯类的关键化合物是酰基辅酶A。辅酶A存在于酵母体内,酯类是脂肪酸渗入酵母细胞内形成的。形成的酯一部分通过细胞膜返回发酵液内,另一部分被酵母吸附,滞留于细胞体内。酯类对啤酒风味的重要性大于高级醇,对酒香味有重要影响。但是和啤酒中其他风味物质组分一样,酯类的含量太高将会使啤酒产生一种水果或糖果似的风味,但是含量太高会给啤酒一种苦味。
双乙酰
双乙酰是影响啤酒成熟的重要物质,其含量是品评啤酒是否成熟的主要依据。一般情况下,在下面发酵啤酒中双乙酰的阈值是0.1-0.2mg/kg,而在上面发酵啤酒或烈性黑啤酒中,其阈值是0.1mg/kg或0.4mg/kg。当啤酒中双乙酰含量达到其阈值时就能辨别出一种酸的烧焦的麦芽味,当其含量超过阈值过高时就能辨别出典型的双乙酰味,似馊饭味。
硫化物
硫化物主要有硫化氢、硫醇、二甲基硫、含硫蛋白质、硫基丙氨酸、蛋氨酸和肽类等。啤酒中的硫化合物部分来自原料,如酒花在干燥时,为了增强其保存性,常用硫黄熏蒸措施;在麦芽制造和麦汁制备过程中也可能产生一些挥发性硫化物。成品啤酒中的含硫化合物绝大部分是在发酵过程中形成的。首先,啤酒酵母对硫酸盐的代谢作用形成硫化氢,硫化氢再进一步和发酵液中的氮代谢产物及碳水化合物代谢产物反应生成挥发性含硫化合物。与啤酒风味关系最大的硫化氢和二甲基硫。硫化氢被日光曝晒易发生日光臭。啤酒中的硫化氢的形成主要是由于酵母对半胱氨酸、硫酸盐和亚硫酸盐的同化作用和酵母合成蛋氨酸受抑制时,所生成的中间产物。啤酒需要适度的二甲基硫含量,但含量太多时则使啤酒的风味不正常,一般超过100ug/L就会使啤酒的风味变坏。二甲基硫的产生一方面来自原料麦芽在发芽过程产生的,另一方面是经酵母代谢而形成的。
脂肪酸和有机酸
脂肪酸作为酵母代谢产物,主要是在发酵的最初3-4天与相应的高级醇同时形成的,前驱物质都是相应的醛类。上面发酵啤酒的脂肪酸含量较下面发酵啤酒高1/3,啤酒中脂肪酸的含量由于原料、菌种和发酵条件不同而异。
啤酒中的有机酸包括乳酸、琥珀酸、柠檬酸、苹果酸、异柠檬酸及有关的酮酸等 ,这些有机酸多数对啤酒风味有一定的影响,有的存在于麦芽醪中,有的是酵母细胞内正常代谢产物。



啤酒作证,上帝是爱我们的!






